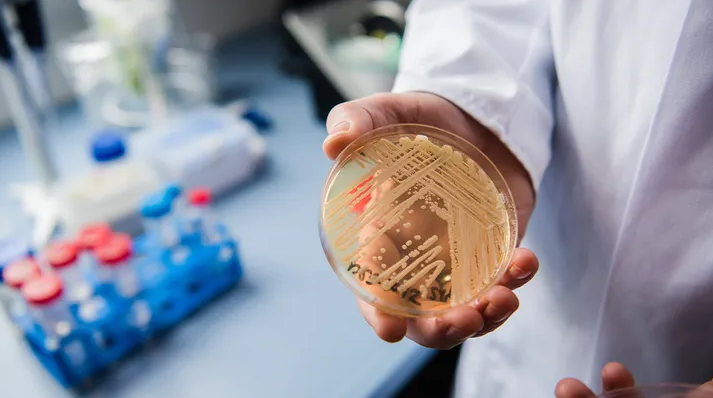
Alerta de Salud Urgente: Mortal ‘Superhongo’ se Propaga por EE.UU., Representando una Grave Amenaza para Pacientes Vulnerables

NOTICIAS NACIONALES
Ver todo






NOTICIAS INTERNACIONALES
Ver todo






LOCALES / REGIONALES
Ver todo








ÚLTIMA EDICIÓN
ÚLTIMAS NOTICIAS

Katy Perry es Investigada por la Policía Tras la Impactante Denuncia de Agresión Sexual de Ruby Rose
Por María José RuízLa Policía de Victoria ha confirmado una investigación sobre una denuncia hi…

Trump Publica Otra Bizarra Foto de Jesús y la Califica de "Bastante Bonita" Mientras Escala la Controversia Religiosa
Por María José RuízEl presidente Trump compartió una imagen generada por IA de sí mismo como Je…

Doctor es Acusado por Extraer el Hígado en Lugar del Bazo, Matando a un Veterano de la Marina; Continuó Practicando para el Ejército a Pesar de Errores "Atroces"
Por María José RuízUn gran jurado de Florida acusó al Dr. Thomas Shaknovsky de homicidio culposo…
Nueva Acusadora Dice que el Ex Congresista Eric Swalwell la Agredió Sexualmente en 2018
Por James FritchUna mujer ha declarado que el ex congresista de California Eric Swalwell la drogó y…

Robots Humanoides se Preparan para la Segunda Media Maratón en Beijing con Pruebas Nocturnas que Prueban Nuevas Capacidades
Por James FritchRobots humanoides se sometieron a pruebas nocturnas en Beijing antes de la segunda m…
Video
Más Allá del Aula: Estudiantes y Profesores de Brandeis se Preparan para Programas de Verano Alrededor del Mundo
Por María José RuízDesde salud pública en México hasta física de glaciares en Islandia, los es…

Vecinos de Diddy en Los Ángeles Temen "Caos" si se Anula su Condena y Regresa a Casa
Por María José RuízResidentes del exclusivo vecindario Holmby Hills de Los Ángeles están preocu…

Ex Alcalde de Nueva York Eric Adams Recibe Ciudadanía Albanesa por Decreto Presidencial
Por María José RuízEl ex alcalde de la ciudad de Nueva York, Eric Adams, recibió la ciudadanía …

Policías Matan a Tiros a Hombre Armado con Machete que Hirió a 3 Ancianos en la Estación Grand Central
Por María José RuízUn hombre de 44 años que gritaba "Soy Lucifer" fue abatido por detectives del…

Trump Arremete Contra los "Corruptos y Locos Medios Fake News" por su Cobertura de la Guerra contra Irán
Por María José RuízEl presidente Trump arremetió contra los medios de comunicación por su cober…

Un Incendio Masivo Destroza un Dúplex en Fairview, Nueva Jersey; Un Herido de Gravedad y Siete Desplazados
Por Uyime EkefreUn incendio de cuatro alarmas arrasó con una vivienda de dos familias en Fairview, …
Última Hora de la Guerra Irán-EE.UU.: Trump Amenaza con Tomar "Fácilmente" la Isla de Kharg mientras el Petróleo se Encamina a un Alza Mensual Récord
Por Uyime EkefreAl entrar la guerra entre EE.UU.-Israel e Irán en su quinta semana, el presidente T…

Última Hora: Se Disparan los Precios Internacionales del Petróleo—WTI Supera los $100, Brent Alcanza los $114
Por Uyime EkefreLos precios globales del petróleo se han disparado mientras el crudo WTI supera los…

Irán Advierte a Trump: Atacan Nuestras Plantas Eléctricas y Cerraremos por Completo el Estrecho de Ormuz
Por Uyime EkefreEn una respuesta encendida al ultimátum de 48 horas del presidente Trump, Irán adv…

El Senador Markwayne Mullin Supera Obstáculo Clave en su Camino a Ser el Próximo Secretario de Seguridad Nacional
Por Uyime EkefreEl senador republicano de Oklahoma, Markwayne Mullin, superó una votación de prueb…